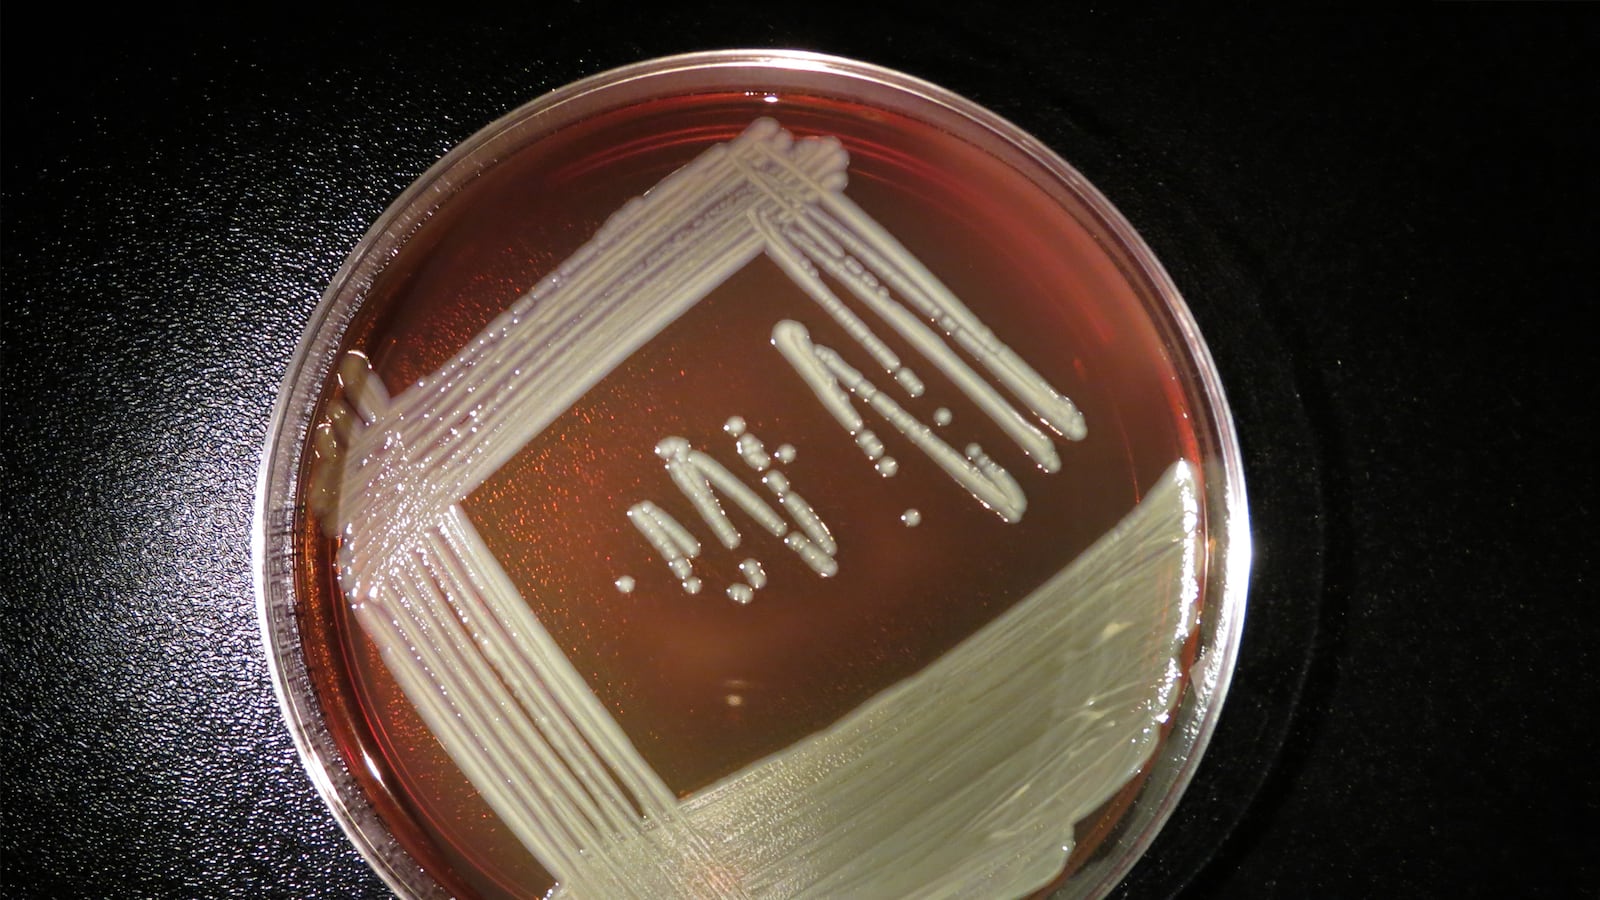
articles/2016/03/22/what-is-elizabethkingia-the-strange-blood-infection-gripping-the-midwest/160321-allen-blood-infection-tease_fd40rl

Elizabethkingia is killing people in Wisconsin. It could be spreading to Michigan. But no one knows where it came from.
The unusual bacteria—named after the late American microbiologist Elizabeth O. King—can, in rare cases, lead to a life-threatening bloodborne illness marked by fever, shortness of breath, chills, or skin infection. Not only is it resistant to many antibiotics and potentially deadly for immunocompromised patients, health officials have yet to locate the origin of this latest outbreak.
Between Nov. 1, 2015, and March 16, 2016, the Wisconsin Department of Health Services (DHS) has received 54 reports of Elizabethkingia infections, exclusively occurring in patients with an “underlying serious illness,” most of them over the age of 65. So far, it has been linked to 17 deaths in the state—early estimates of 18 total deaths have since been lowered. The Wisconsin DHS told The Daily Beast that the median age of those who have died is 77 years old.
On March 11, Michigan saw its first case, also in an older adult. Six days later, the Michigan Department of Health and Human Services (MDHHS) announced the death of that patient. MDHHS told The Daily Beast that they are not “disclosing any additional details about the individual due to privacy concerns.”In conjunction with the Centers for Disease Control and Prevention (CDC), the Wisconsin DHS has been looking for the mysterious bacteria in water sources, health-care facilities, and environmental sources.
“To date, none of these have found to be a source of the bacteria,” the department noted in a statement.
The CDC is shocked by the size of the outbreak and by the total number of fatalities. In contrast to past Elizabethkingia outbreaks, it is large and dispersed across a wide area.
Michael Bell, deputy director of the CDC’s Division of Healthcare Quality Promotion, told The Washington Post this month that the Wisconsin Elizabethkingia outbreak is “one of the largest that I’m aware of and certainly the largest one we’ve investigated.” As the Post notes, all of the cases identified so far have the same genetic footprint, which suggests that the entire outbreak can be attributed to a single source.
But the full range of potential origins means that public health officials are looking for a single bacterial needle in a haystack of possibilities.
Water was ruled out relatively early on. Dr. Christopher Braden, deputy director of the CDC’s National Center for Emerging and Zoonotic Infectious Diseases, told the Wisconsin State Journal in early March that the affected patients were using different water supplies and some were using wells. Unless the bacteria were somehow present in all of these sources, it’s unlikely that the outbreak is waterborne. The Wisconsin DHS told The Daily Beast that the agency is “reasonably certain groundwater is not the source.”
Indeed, the geographical layout of the outbreak has investigators scratching their heads. The Wisconsin DHS has received reports of cases in 12 counties, concentrated in the southeastern region of the state. The first case in Michigan, which borders Wisconsin on the east, occurred in the western part of the state. If they were clustered in a single hospital instead—as is more often the case in Elizabethkingia-associated outbreaks—this mystery would be much easier to solve.
“These patients are in different places around southeastern Wisconsin,” Dr. Braden told the Minneapolis Star Tribune. “There’s no commonality for some particular environmental exposure that people had.”
In the absence of an obvious environmental source, Braden said that investigators are also “looking hard at all sorts of different products that these people may have been exposed to—personal care products or medical products.” But given the full range of “things you put on your skin or you ingest in some way each day,” he believes that locating a common product among the dozens of reported cases will take time.
As the MDHHS notes, most bacterial disease outbreaks caused by Elizabethkingia are “healthcare-associated.” Because of the bacteria’s resistance to antibiotics, the agency warns that infections must be caught early on to prevent serious complications, especially among patients with underlying health conditions.
With the illness now crossing state lines, the pressure is on to locate its point of origin—and fast. But as of March 21, the CDC had no new updates to share. A spokesperson told The Daily Beast that the agency “has been testing all kinds of different things” including “healthcare products, water sources, [and] environmental samples” but so far, no luck.